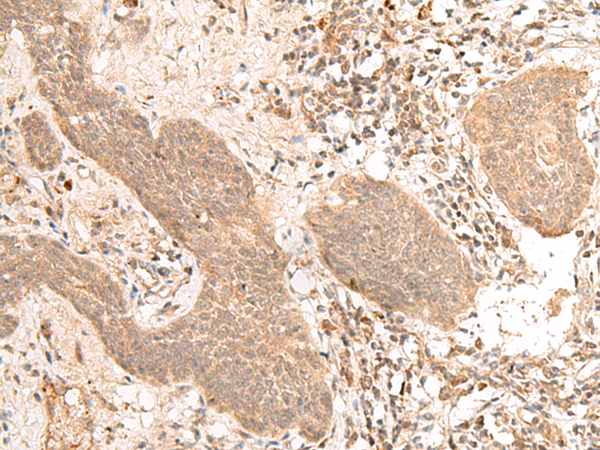

-
分类: 科研抗体货号: P13416别名: VPS54L; CCDC132应用: IHC反应种属: Human, Mouse, Rat
-
分类: 科研抗体货号: P13395别名: FBL7; CXXC8; FBL11; FBXL11; JHDM1A; LILINA应用: IHC反应种属: Human, Mouse
-
分类: 科研抗体货号: P13414别名: ZNF798应用: IHC反应种属: Human, Mouse
-
分类: 科研抗体货号: P13394别名: FBX9; VCIA1; NY-REN-57; dJ341E18.2应用: WB,IHC反应种属: Human, Mouse, Rat
-
分类: 科研抗体货号: P13413别名: SRC2; c-fgr; c-src2; p55-Fgr; p58-Fgr; p55c-fgr; p58c-fgr应用: IHC反应种属: Human
-
分类: 科研抗体货号: P13393别名: FA2; FAB; FACB; FAAP90; FAAP95应用: WB,IHC反应种属: Human
-
分类: 科研抗体货号: P13412别名:应用: IHC反应种属: Human
-
分类: 科研抗体货号: P13392别名: KMIN; hFAN1; MTMR15; KIAA1018应用: IHC反应种属: Human
-
分类: 科研抗体货号: P13410别名: FHF3; FHF-3; FGF-11应用: IHC反应种属: Human, Mouse
-
分类: 科研抗体货号: P13390别名:应用: IHC反应种属: Human, Mouse

鄂公网安备42018502007531号
鄂公网安备42018502007531号

